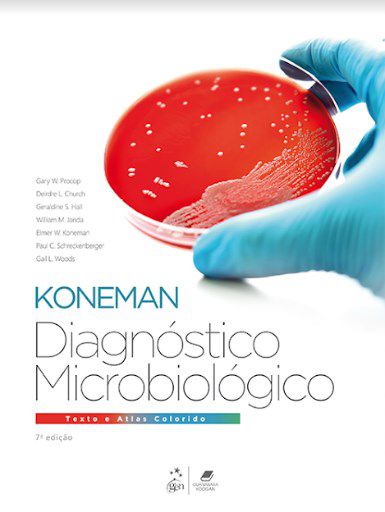
Livro Diagnóstico Microbiológico Texto e Atlas Colorido Koneman

Livro Diagnóstico Microbiológico Texto e Atlas Colorido Koneman
-
- 1x de R$ 1.114,00 sem juros
- 2x de R$ 557,00 sem juros
- 3x de R$ 371,33 sem juros
- 4x de R$ 278,50 sem juros
- 5x de R$ 222,80 sem juros
- 6x de R$ 185,66 sem juros
- 7x de R$ 159,14 sem juros
- 8x de R$ 139,25 sem juros
- 9x de R$ 123,77 sem juros
- 10x de R$ 111,40 sem juros
- 11x de R$ 101,27 sem juros
- 12x de R$ 92,83 sem juros
-
- 1x de R$ 1.114,00 sem juros
- 2x de R$ 610,69
- 3x de R$ 413,03
- 4x de R$ 310,14
- 5x de R$ 254,68
- 6x de R$ 212,25
- 7x de R$ 185,75
- 8x de R$ 162,55
- 9x de R$ 148,15
- 10x de R$ 134,40
- 11x de R$ 122,20
- 12x de R$ 113,36
-
R$ 1.058,30

ISBN 9788527733182
Edição 7
Ano 2018
Idioma Português
Autor Alen Koneman
Páginas 1860
Encadernação
Diagnóstico Microbiológico Texto e Atlas é uma fonte abrangente e de fácil compreensão, que proporciona cobertura atualizada sobre bacteriologia, micologia, parasitologia e virologia, além de um atlas com imagens de alta qualidade. Foram incorporados, nesta edição, os avanços substanciais que ocorreram na área da microbiologia clínica desde a edição anterior, como a espectrometria de massa MALDI-TOF e os testes de amplificação do ácido nucleico de fácil realização. O livro é uma referência para alunos, professores e profissionais de laboratório. Principais características: Correlações clínicas: os Quadros de Correlações Clínicas fazem uma ponte entre os microrganismos e as doenças a eles relacionadas por meio da utilização da mais atual literatura médica. Quadros clínicos são utilizados para demonstrar como a microbiologia é aplicada em situações reais. Pranchas coloridas ilustram microrganismos de relevância de modo a auxiliar em sua identificação.
Índice:
"1) Introdução à Microbiologia - Parte I: O Papel do Laboratório de Microbiologia no Diagnóstico das Doenças Infecciosas: Orientações para a Prática e Conduta 2) Introdução à Microbiologia - Parte II: Orientações para a Coleta, Transporte, Processamento, Análise e Relato de Culturas de Fontes Específicas de Amostras 3) Diagnóstico Laboratorial por Métodos Imunológicos 4) Microbiologia Molecular 5) Bacteriologia Médica: Taxonomia, Morfologia, Fisiologia e Virulência 6) As Enterobacteriaceae 7) Bacilos Gram-Negativos Não-Fermentadores 8) Bacilos Gram-Negativos Curvos e Fermentadores Oxidase-Positivos: Campylobacteraceae e Vibrionaceae 9) Bacilos Gram-Negativos Exigentes 10) Legionella 11) Espécies de Neisseria e Moraxella catarrhalis 12) Cocos Gram-Positivos - Parte I: Estafilococos e Cocos Gram-Positivos Relacionados 13) Cocos Gram-Positivos - Parte II: Estreptococos, Enterococos e Bactérias Semelhantes a Estreptococo 14) Bacilos Gram-Positivos Aeróbicos e Facultativos 15) Actinomicetos Aeróbicos 16) Bactérias Anaeróbicas 17) Teste de Sensibilidade aos Antimicrobianos (Antibiograma) 18) Micoplasmas e Ureaplasmas 19) Micobactérias 20) Infecções por Espiroquetas 21) Micologia 22) Parasitologia 23) Diagnóstico das Infecções Causadas por Vírus, Chlamydia, Rickettsia e Microrganismos Relacionados Apêndices Apêndice I - Ectoparasitas e Outros Invertebrados no Laboratório Clínico: Um Breve Guia Apêndice II - Amebas de Vida Livre Quadros Pranchas Coloridas Índice Alfabético"
Produtos relacionados
-
 Livro Atlas de DST e Diagnóstico DiferencialR$ 1.139,99até 12x de R$ 94,99 sem jurosou R$ 1.082,99 via Boleto Bancário
Livro Atlas de DST e Diagnóstico DiferencialR$ 1.139,99até 12x de R$ 94,99 sem jurosou R$ 1.082,99 via Boleto Bancário -
 Livro Microbiologia TortoraR$ 526,00até 12x de R$ 43,83 sem jurosou R$ 499,70 via Boleto Bancário
Livro Microbiologia TortoraR$ 526,00até 12x de R$ 43,83 sem jurosou R$ 499,70 via Boleto Bancário -
 Livro Microbiologia Veterinária
Livro Microbiologia VeterináriaR$ 628,00R$ 490,90até 12x de R$ 40,90 sem jurosou R$ 466,36 via Boleto Bancário22% Desconto -
 Livro Microbiologia Pratica: Aplicacoes de Aprendizagem de Microbiologia Basica - - Ribeiro/stelatoR$ 209,00até 10x de R$ 20,90 sem jurosou R$ 198,55 via Boleto Bancário
Livro Microbiologia Pratica: Aplicacoes de Aprendizagem de Microbiologia Basica - - Ribeiro/stelatoR$ 209,00até 10x de R$ 20,90 sem jurosou R$ 198,55 via Boleto Bancário
-
A Livro Pro é uma livraria especializada em livros técnicos e didáticos, com atuação focada nas áreas da saúde, direito, ciências humanas e ciências exatas. Nosso catálogo é cuidadosamente selecionado para atender às necessidades de estudantes, professores, pesquisadores e profissionais, oferecendo obras atualizadas, reconhecidas academicamente e alinhadas às exigências do mercado e da formação educacional. Trabalhamos com conteúdos que apoiam a graduação e pós-graduação até a atualização profissional!